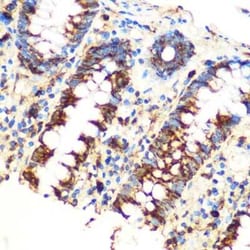
SAV1 Rabbit anti-Human, Mouse, Rat, Polyclonal, Novus Biologicals:Antibodies:Primary

missing translation for 'onlineSavingsMsg'
Learn More
Learn More
SAV1 Rabbit anti-Human, Mouse, Rat, Polyclonal, Novus Biologicals™
Rabbit Polyclonal Antibody
£183.00 - £378.00
Specifications
| Antigen | SAV1 |
|---|---|
| Dilution | Western Blot, Immunohistochemistry 1:50 - 1:200, Immunohistochemistry-Paraffin, Knockout Validated |
| Applications | Western Blot, Immunohistochemistry, Immunohistochemistry (Paraffin), KnockDown |
| Classification | Polyclonal |
| Conjugate | Unconjugated |
| Product Code | Brand | Quantity | Price | Quantity & Availability | |||||
|---|---|---|---|---|---|---|---|---|---|
| Product Code | Brand | Quantity | Price | Quantity & Availability | |||||
|
18375764
|
Novus Biologicals
NBP3-15584-20UL |
20 μg |
£183.00
20µL |
Please sign in to purchase this item. Need a web account? Register with us today! | |||||
|
18307373
|
Bio-Techne
NBP3-15584-100UL |
100 μg |
£378.00
100µL |
Please sign in to purchase this item. Need a web account? Register with us today! | |||||
Description
SAV1 Polyclonal antibody specifically detects SAV1 in Human, Mouse, Rat samples. It is validated for Western Blot, Immunohistochemistry, Immunohistochemistry (Paraffin), KnockDownSpecifications
| SAV1 | |
| Western Blot, Immunohistochemistry, Immunohistochemistry (Paraffin), KnockDown | |
| Unconjugated | |
| Rabbit | |
| Cell Biology, Signal Transduction | |
| PBS, 50% glycerol, pH7.3 | |
| 60485 | |
| IgG | |
| Affinity purified |
| Western Blot, Immunohistochemistry 1:50 - 1:200, Immunohistochemistry-Paraffin, Knockout Validated | |
| Polyclonal | |
| Purified | |
| RUO | |
| Human, Mouse, Rat | |
| 45 kDa WW domain protein, hWW45, protein salvador homolog 1, salvador homolog 1 (Drosophila), SAV, WW domain-containing, WW45salvador, WWP4,1700040G09Rik | |
| Recombinant fusion protein containing a sequence corresponding to amino acids 199-383 of human SAV1 (NP_068590.1). | |
| Primary | |
| Store at -20°C. Avoid freeze-thaw cycles. |
Spot an opportunity for improvement?Share a Content Correction
Product Content Correction
Your input is important to us. Please complete this form to provide feedback related to the content on this product.
Product Title